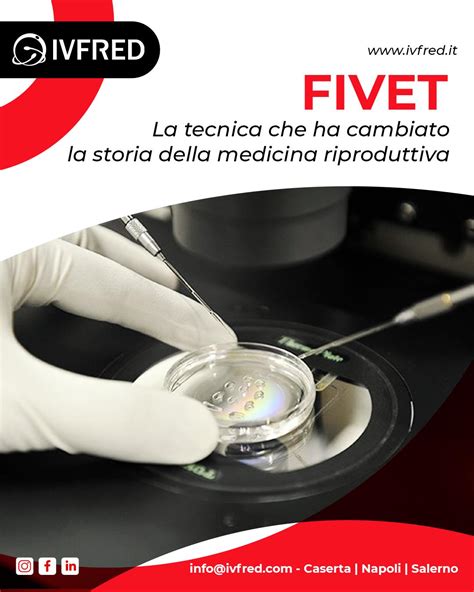
Strumenti medici per il monitoraggio ormonale in laboratorio

Negli ultimi anni, il monitoraggio dell’ovulazione è diventato un gesto quotidiano per moltissime donne che desiderano conoscere meglio il proprio corpo o cercare una gravidanza in modo più consapevole. L'evoluzione tecnologica ha reso disponibili numerosi strumenti, dai più semplici e immediati ai più avanzati e precisi, capaci di fornire dati affidabili e di interpretarli in modo comprensibile anche per chi non possiede specifiche competenze mediche. Questo approfondimento esplorerà i meccanismi alla base di questi dispositivi, delineando le diverse metodologie e offrendo una panoramica completa sul loro utilizzo e le loro potenzialità.
La Fisiologia del Ciclo Mestruale e la Finestra Fertile
Per comprendere come funzionano gli strumenti di monitoraggio dell'ovulazione, è fondamentale conoscere il processo biologico che regola la fertilità femminile. Dalla pubertà alla menopausa, ogni mese, il corpo femminile si prepara a un'eventuale gravidanza. Se questa non avviene, compare una nuova mestruazione. Il ciclo mestruale, che dura in genere 28 giorni ma può corrispondere anche a un periodo di tempo inferiore o superiore, è scandito da fasi ben definite.
Il giorno in cui iniziano le mestruazioni (primo giorno di flusso mestruale completo) è il Giorno 1. Dal secondo giorno dall'inizio delle mestruazioni, comincia la cosiddetta fase follicolare: i follicoli che portano a maturazione la cellula uovo si attivano nuovamente, sia per far maturare l'ovocita, sia per provvedere alla sintesi degli ormoni, in particolare gli estrogeni, necessari per ricostituire l'endometrio.
Intorno al 14° giorno si verifica l'ovulazione, momento in cui può avvenire la fecondazione. Durante questo periodo, l’organismo cerca di favorire in tutti i modi la fecondazione, anche attraverso la produzione di ormoni specifici. Dopo il rilascio della cellula uovo matura, il follicolo si trasforma nel corpo luteo, che produce progesterone, per predisporre la parete interna dell'utero (endometrio) all'eventuale impianto, nel caso si verificasse il concepimento (fase luteale).
Durante ogni ciclo mestruale, i giorni in cui può avvenire il concepimento sono limitati. Infatti, sono solo pochi i giorni in cui la donna è fertile, e non sempre è facile individuarli con esattezza. Il periodo in cui è possibile che l'uovo venga fecondato inizia 4-5 giorni prima dell'ovulazione e termina 1-2 giorni dopo. Ciò è possibile in considerazione del fatto che la cellula uovo matura, quando viene espulsa dall'ovaia, riesce a sopravvivere per circa 24 ore, mentre gli spermatozoi possono rimanere vitali nell'apparato genitale femminile fino a 72-96 ore. Pertanto, un rapporto sessuale avvenuto anche 3 o 4 giorni prima dell'ovulazione può portare alla fecondazione. In alcune condizioni, può essere utile identificare la finestra fertile in modo da avere rapporti mirati all’ovulazione. Il test di ovulazione è uno strumento molto utile per individuare i giorni fertili all’interno del ciclo mensile di una donna, ossia i giorni in cui la probabilità di rimanere incinta è più elevata.

Monitoraggio dell'Ovulazione: Dalle App ai Dispositivi Avanzati
Il monitoraggio dell’ovulazione non serve solo a favorire una gravidanza: è anche un modo per prendersi cura di sé, individuare eventuali irregolarità e affrontare con maggiore serenità le diverse fasi della vita fertile. Il test di ovulazione è un importante supporto nel caso della ricerca di una gravidanza o anche se si vuole evitarla senza ricorrere ai tradizionali metodi anticoncezionali.
Il primo approccio per molte donne è spesso rappresentato dalle app per smartphone, facili da usare e capaci di fornire previsioni dettagliate del periodo fertile. Per chi desidera un monitoraggio più avanzato, esistono oggi anche dispositivi specifici che analizzano i livelli ormonali o i dati fisiologici durante il sonno. La scelta dello strumento più adatto dipende da molti fattori: alcuni preferiscono l’immediatezza delle app gratuite, altri si affidano alla precisione dei dispositivi fisici, che però possono avere un costo maggiore. Naturalmente, ogni donna ha esigenze diverse e non esiste un metodo migliore in assoluto.
Calcolare l'ovulazione: Il miglior momento per restare incinta
Test di Ovulazione Basati sull'Urna: Rilevazione degli Ormoni Chiave
La maggior parte dei test di ovulazione si basa sull'analisi dell'urina per rilevare i cambiamenti nei livelli ormonali. Quello che accomuna quasi tutti i test di ovulazione è l’analisi dell’urina. Il test dell'ovulazione si basa sul riscontro, nelle urine della donna, dei cambiamenti dei livelli dell'ormone luteinizzante (LH), prodotto dall'adenoipofisi e fondamentale per la fertilità. Questo ormone viene secreto durante tutto il ciclo mestruale, ma aumenta 24-36 ore prima della fase ovulatoria, per indurre la maturazione finale della cellula uovo femminile. Quando si riscontra un esito positivo, significa che l'ormone luteinizzante (LH) ha raggiunto un'elevata concentrazione, quindi la fase ovulatoria del ciclo mestruale è imminente e ci si trova nel momento più fertile.
Oltre ad aiutare a capire quando si verifica il picco dell'ormone luteinizzante (LH), alcuni test misurano anche i livelli di estrogeni, in particolare di estradiolo, ormoni che favoriscono il concepimento.
Esistono diverse tipologie di test di ovulazione urinari:
- Penne Analogiche e Strisce Reattive: Le penne analogiche sono monouso e possono essere utilizzate solo per un test. Molto ricercati e quasi introvabili se non online, i test di ovulazione canadesi sono anche i test di ovulazione più economici sul mercato: si presentano come delle strisce reattive che si colorano a seconda delle presenza o meno dell’ovulazione. I test di ovulazione canadesi rivelano i livelli di ormone LH. Gli stick "canadesi" hanno un ottimo rapporto tra qualità e prezzo: di fronte a un’ottima affidabilità, il costo è di pochi centesimi. Sono quindi adatti per l’uso continuativo e per i cicli molto lunghi, nei quali una sola scatola di stick tradizionali non basterebbe. La maggior parte dei test di ovulazione contiene da cinque a sette strisce o tamponcini, in formato monouso, in grado di rilevare la presenza dell'ormone luteinizzante (LH) nelle urine.
- Test Digitali per Ovulazione: Tra i più utilizzati troviamo i test digitali per ovulazione che rilevano il picco dell’ormone LH nelle urine. Gli stick digitali facilitano la lettura, in quanto è sufficiente interpretare il risultato positivo o negativo in corrispondenza della finestrella per l'ormone luteinizzante (o per l'LH e gli estrogeni), per capire se si è o meno nel periodo fertile. I monitor di fertilità sono apparecchi più complessi, dal costo decisamente superiore, ma che possono essere riutilizzati per lungo tempo. In genere, oltre che per identificare i giorni più favorevoli per una gravidanza, sono molto utilizzati anche come metodo anticoncezionale naturale.
- Stick per Computer/Monitor di Fertilità: Questi identificano la finestra fertile e costano meno della metà dei precedenti (sono disponibili in farmacia sotto forma di ricariche per il dispositivo vero e proprio).
Modalità d'Uso dei Test Urinari
Per eseguire il test, la punta assorbente del dispositivo va posizionata verso il basso, esponendola al flusso di urina per 5-7 secondi. In alternativa, è possibile raccogliere un campione di urina in un contenitore pulito e asciutto, quindi immergervi la punta assorbente del test per 15 secondi. Entro 3-10 minuti, la finestrella o il display digitale del dispositivo mostrerà il risultato. L'ideale è ripetere le misurazioni sempre alla stessa ora, possibilmente al mattino appena sveglie, o comunque dopo almeno 3-4 ore dall'ultima minzione. Nelle ore precedenti è importante bere poco, per non falsare la lettura. Per ottenere risultati attendibili, è consigliabile utilizzare la prima urina del mattino o comunque le urine raccolte dopo il periodo di sonno più lungo. Il metodo dev'essere ripetuto per alcuni giorni, considerando la data in cui è più probabile che avvenga l'ovulazione. Se l’esito del test è negativo vuol dire che i livelli di ormoni sono ancora troppo bassi per essere rilevati e, dunque, si è ancora lontani dalla fase di ovulazione.
I test dell'ovulazione devono essere utilizzati quotidianamente da due a quattro giorni prima della presunta data di ovulazione. Prima di cominciare, quindi, è fondamentale conoscere la durata abituale del proprio ciclo mestruale, al fine di eseguire il test nel momento opportuno per la rilevazione del picco di ormone luteinizzante (LH). La durata del proprio ciclo mestruale si calcola contando dal giorno in cui hanno inizio le mestruazioni (giorno 1) fino al giorno prima dell'inizio del flusso mestruale successivo; il numero calcolato corrisponde alla durata complessiva del proprio ciclo. Se la durata del proprio ciclo mestruale non è ancora nota, è opportuno attendere di avere almeno un ciclo, prima di iniziare ad utilizzare i test dell'ovulazione.
In un ciclo regolare di 28 giorni, di solito, il giorno di massima fertilità corrisponde al quattordicesimo. Per averne la certezza, si può ricorrere già a partire dall'undicesimo giorno al test di ovulazione, che andrà ripetuto fino a quando il risultato non sarà positivo. Tuttavia, occorre sapere che non tutte le donne hanno un ciclo regolare: in molti casi, la prima parte del ciclo dura di più o di meno, per cui diventa difficile capire quando si sta attraversando la fase fertile. I test di ovulazione vanno eseguiti per una media di tre giorni. Se al mattino la prova risulta positiva si può calcolare che l'ovulazione avverrà nel corso della giornata o entro la giornata successiva. Il primo esito positivo indica che sta per verificarsi l'ovulazione. Per questo motivo, si dovrebbe iniziare a fare i test prima del periodo in cui è prevista la fase ovulatoria, in quanto il picco di ormone luteinizzante potrebbe non essere altrimenti evidente.
Gli stick vanno fatti a giorni alterni, finché non compare una seconda linea più tenue, da quel giorno in poi verranno fatti tutti i giorni fino al segnale di ovulazione (poi ovviamente si può sospendere). Lo stick è francamente positivo quando appaiono due linee ben nette e di pari intensità. Si bagna la parte “attiva” dello stick con le urine del mattino. Si mette lo stick su un ripiano e si aspettano un paio di minuti per la lettura (oltre i 10 minuti il risultato potrebbe non essere attendibile). Per i test canadesi, vanno utilizzati a partire da circa 16 giorni prima dell’arrivo previsto del ciclo. Il giorno di inizio degli stick dipende dalla durata del ciclo, in genere si consiglia di iniziare comunque dal 5-6° giorno del ciclo (dall’8-9° in chi ha cicli molto lunghi), in modo da non perdere un picco ovulatorio precoce e non scambiare quindi il ciclo per anovulatorio.

Il "Clearblue Test di Ovulazione Digitale Avanzato" e l'Interpretazione dei Risultati
Il "Clearblue Test di Ovulazione Digitale Avanzato" è un test in grado di identificare una media di 4 giorni fertili per ciascun ciclo. Attraverso il suo algoritmo, il test si adatta al tuo specifico profilo ormonale, riducendo le probabilità di errore nell'individuazione dei giorni fertili. Il test rileva i livelli ormonali individuali e il primo giorno di ogni ciclo in cui viene eseguito il test rileverà il livello di estrogeno. Il test non può segnalare una fertilità elevata il primo giorno del test, perché ha bisogno di determinare il livello basale. I test successivi utilizzano questo livello basale, segnalando il periodo di fertilità elevata quando rilevano un aumento significativo dell'estrogeno. Il test segnalerà quindi una fertilità elevata fino al rilevamento del picco di LH, momento in cui mostrerà l’indicazione di picco di fertilità.
Per la lettura dei risultati, il display o la finestrella mostrerà:
- Fertilità bassa: Un cerchio vuoto indica fertilità ridotta.
- Fertilità elevata: Una faccina sorridente lampeggiante indica fertilità elevata. Quando il dispositivo rileva un aumento del livello di estrogeno, il display indica che la fertilità è elevata (faccina sorridente lampeggiante), indicazione che rimarrà anche i giorni successivi, fino al rilevamento del picco di LH.
- Picco di fertilità (Fertilità più elevata): Una faccina sorridente fissa indica i due giorni di fertilità più elevata. Avere rapporti sessuali durante quei giorni aumenta le probabilità di concepimento.
Se si desidera un bambino, è possibile iniziare ad avere rapporti sessuali non protetti, in modo da ottimizzare le probabilità di rimanere incinta. Il picco di fertilità (faccina sorridente fissa) non scompare. Non è possibile eseguire un altro test durante l’indicazione di più elevata fertilità, in quanto il portastick non sarà in grado di leggere il risultato. Registra i risultati del test di ovulazione e monitora i tuoi cicli e sintomi. Se si rimuovono le batterie dal portastick, non sarà più possibile utilizzare il dispositivo. È bene eseguire il test al più presto, evitando però di bere molti liquidi prima di effettuare il test.
Questo test contiene un numero di stick sufficiente per rilevare il periodo di fertilità elevata e più elevata della maggior parte delle donne con cicli regolari. Se la durata del ciclo è lunga o variabile, potrebbe essere necessario eseguire più test. Alcune donne potrebbero non vedere i giorni di fertilità elevata ma solo quelli di fertilità più elevata. Questo può succedere perché il livello di estrogeno non è abbastanza alto da essere rilevato dal test, oppure perché si è iniziato a eseguire il test troppo tardi. I livelli ormonali e la durata del ciclo variano da donna a donna e anche da ciclo a ciclo in una stessa donna.
Se si esegue il test il giorno giusto in base alla durata del proprio ciclo e si osservano 9 o più giorni di fertilità elevata, è probabile che per quel ciclo non verrà indicato il picco di fertilità. Talvolta, alcune donne hanno un picco di LH troppo basso per essere rilevato dal test, oppure è possibile che non avvenga l’ovulazione durante quel ciclo, e in questo caso si potrebbero osservare molti giorni di fertilità elevata ma nessun giorno di picco di fertilità.

Dispositivi Indossabili e Sensori Avanzati: Monitoraggio Continuo dei Dati Fisiologici
Per chi cerca un monitoraggio ancora più sofisticato, esistono braccialetti e sensori indossabili, come Ava o Tempdrop, capaci di monitorare la temperatura basale, la frequenza cardiaca e la qualità del sonno. Questi dispositivi digitali permettono infatti di raccogliere dati affidabili e, soprattutto, di interpretarli in modo semplice.
Un esempio di dispositivo avanzato è OvulaRing, che misura la temperatura corporea centrale 24/7, per pattern di ovulazione e fertilità calcolati in modo preciso e personalizzato. Certificato come dispositivo medico, OvulaRing è adatto all’uso quotidiano. Il principio di misurazione si basa sulla temperatura corporea centrale continua, a differenza della misurazione singola quotidiana o notturna della temperatura basale (BBT/STM) e dell'osservazione del muco cervicale. OvulaRing può supportare al meglio nella contraccezione naturale, ma per evitare con certezza una gravidanza è necessario un metodo contraccettivo a scelta.
Molte donne hanno trovato in OvulaRing un valido aiuto. Ad esempio, Nicole, dopo aver cercato per otto anni di rimanere incinta e aver ricevuto diagnosi di sindrome dell’ovaio policistico (PCOS) per sé e spermiogramma sfavorevole per il marito, e dopo diversi cicli di terapia ormonale senza successo, ha scoperto con OvulaRing che, nonostante la PCOS, ovulava. Sapendo quando avveniva l’ovulazione, è rimasta incinta due volte, in modo del tutto naturale. Altre testimonianze sottolineano come OvulaRing abbia aiutato a conoscere meglio il proprio ciclo mestruale e il proprio corpo, specialmente dopo aver smesso la pillola o in presenza di PCOS. Le domande ricevono sempre risposte dettagliate e tempestive, e l'app è super facile da usare. Con un ciclo molto irregolare, il timing è fondamentale e OvulaRing può dare un buon supporto; tuttavia, si consiglia, in caso di cicli irregolari, di usare anche i test di ovulazione, per avere ancora più sicurezza, perché con forti oscillazioni la temperatura da sola non è sempre indicativa.
Un altro esempio di tecnologia indossabile è l'Apple Watch Series 8 o successivi e tutti i modelli di Apple Watch Ultra, che usano i dati relativi alla temperatura del polso per rilevare il cambiamento bifasico, vale a dire un aumento della temperatura che spesso si verifica dopo l'ovulazione. Per utilizzare questa funzione, è necessario registrare le mestruazioni in modo accurato nell'app Monitoraggio Ciclo, indossare l'Apple Watch per dormire ogni notte con la full immersion Sonno abilitata e assicurarsi che il cinturino aderisca bene, senza risultare troppo stretto e la parte posteriore dell'Apple Watch sia a contatto con il polso. È necessario indossare l'Apple Watch regolarmente per almeno due cicli in modo da raccogliere i dati relativi alla temperatura del polso di notte. Quando è disponibile una stima del giorno in cui probabilmente è avvenuta l'ovulazione, si riceve una notifica sull'Apple Watch o iPhone, e nell'app Salute su iPhone o nell'app Monitoraggio Ciclo su Apple Watch, la stima relativa all'ovulazione è rappresentata da un ovale di colore viola chiaro all'interno del periodo fertile.
Fattori che Possono Influenzare i Risultati e Limitazioni dei Test
Sebbene i test di ovulazione e i dispositivi di monitoraggio siano strumenti preziosi, è importante essere consapevoli dei fattori che possono influenzarne l'accuratezza e delle loro limitazioni.
- Alterazioni del Ciclo: Il ciclo della donna è, infatti, sottoposto a varie alterazioni: stress, viaggi, terapie mediche, terapie ormonali, ovaio policistico, malattie di vario genere possono quindi alterare l’esito del test. Occorre segnalare, però, che l'incremento dell'LH è una condizione necessaria, ma non sufficiente affinché l'ovulazione avvenga. Infatti, può accadere che i test siano positivi, ma il ciclo sia anovulatorio. Questa circostanza non è infrequente e può verificarsi in alcuni cicli.
- Picco di LH Basso o Assente: Talvolta, alcune donne hanno un picco di LH troppo basso per essere rilevato dal test, oppure non avviene l’ovulazione durante quel ciclo e di conseguenza non compare l’indicazione di fertilità più elevata.
- Diluizione dell'Urna: Prima di eseguire il test di ovulazione, evitare di assumere quantità eccessive di liquidi: se l'urina è troppo diluita gli ormoni non sono ben rilevabili e possono verificarsi dei falsi positivi.
- Condizioni Mediche e Farmaci: Certe condizioni mediche e certi farmaci possono causare risultati fuorvianti. Ad esempio, una gravidanza recente, la menopausa o la sindrome dell'ovaio policistico possono produrre esiti fuorvianti. I falsi positivi possono verificarsi anche nel caso in cui siano stati somministrati alla paziente dei farmaci che stimolano l'ovulazione, contenenti l'ormone luteinizzante (LH) o la gonadotropina corionica umana (hCG). La rilevazione del picco di fertilità, invece, non dovrebbe essere influenzata. In caso di gravidanza recente, prima di utilizzare il test di ovulazione digitale avanzato è bene attendere 2 cicli mestruali naturali e prendere nota della loro durata.
- Uso come Contraccezione: Anche se i test di ovulazione possono essere di grande aiuto nello stabilire i giorni fertili quando si è alla ricerca di una gravidanza, la loro attendibilità come contraccettivi non è sempre elevata. Non è consigliabile utilizzare Monitoraggio Ciclo come metodo anticoncezionale.
- Stime vs. Certezza: Le stime sull'ovulazione sono solo stime e non garantiscono che l'ovulazione sia effettivamente avvenuta. Non è consigliabile utilizzare i dati di Monitoraggio Ciclo per diagnosticare eventuali patologie.
Per evitare errori nell'esecuzione del test dell'ovulazione, è sempre indicato leggere e seguire le istruzioni del produttore riportate nel foglietto illustrativo e sulla confezione. Per ulteriori informazioni e in caso di qualsiasi dubbio consultare il proprio medico o il farmacista.
Il Contesto della Procreazione Medicalmente Assistita e il Monitoraggio Ormonale
In contesti più complessi, come quelli della procreazione medicalmente assistita (PMA), il monitoraggio assume una dimensione ancora più critica e specializzata. In questi casi, la risposta alla stimolazione e il controllo della terapia sono fondamentali per la buona riuscita del ciclo di terapia. I rischi più gravi sono sostanzialmente concentrati nella sindrome da iperstimolazione ovarica. Questo fenomeno, descritto raramente anche in donne non sottoposte alle terapie di procreazione assistita, comporta un discreto aumento volumetrico delle ovaie, con produzione di liquido all’interno dell’addome e comparsa di sintomi soggettivi a volte importanti (dolore, senso di peso, difficoltà alla respirazione, diminuzione della diuresi).
È possibile che la terapia di induzione non induca la crescita di un numero adeguato di follicoli o che il monitoraggio condotto sui livelli ormonali faccia ritenere di non poter prelevare ovociti maturi. I farmaci necessari in questa fase del programma vengono selezionati in base alle specifiche condizioni della coppia e alle esigenze del ciclo. Favorire la risposta ovarica è fondamentale per incrementare le possibilità di gravidanza.
Gli analoghi del GnRH possono essere utilizzati in formulazioni “deposito” (nelle pazienti in cui è attesa una normale risposta ovarica) o “giornaliere” e vengono in genere impiegati nelle procedure che prevedono la soppressione dell’ipofisi prima di iniziare la stimolazione. Gli antagonisti del GnRH possono essere proposti alla paziente che presenta una previsione di risposta ridotta o, al contrario, eccessiva alla terapia di somministrazione. Vengono associati a un estroprogestinico per la sincronizzazione del ciclo e generalmente rendono più breve il periodo di induzione della multiovulazione.
Le gonadotropine (FSH ed LH) sono state una rivoluzione nelle possibilità terapeutiche sia nell’induzione nelle pazienti anovulatorie, sia come terapia per la stimolazione della multiovulazione delle procedure di procreazione assistita. Tra i vantaggi resi possibili dalle nuove molecole ricombinanti, ci sono una maggiore omogeneità dei farmaci, una maggior efficacia clinica e la possibilità di ricorrere a dosi inferiori di farmaco per gravidanza ottenuta, considerando anche un basilare principio di precauzione che ha orientato in modo sempre più deciso verso questa categoria di molecole. I dosaggi giornalieri variano da 75-100 UI in pazienti giovani con eccellente riserva ovarica, sottopeso e con tratto policistico a un massimo di 450 UI/die, limite che non viene in genere superato, anche in pazienti con riserva ovarica compromessa, perché ritenuto inefficace.
Il monitoraggio ecografico e ormonale ha lo scopo di definire la risposta e ridurre per quanto possibile la quantità di gonadotropine somministrate e il rischio di iperstimolazione ovarica. Esiste nell’esperienza degli specialisti un rapporto diretto tra numero di ovociti recuperati e probabilità di successo (bambini nati), anche senza considerare le gravidanze da crioconservazione, che giunge a ridurre l’effetto negativo dell’età. Circa il 30% delle coppie ottiene una gravidanza alla conclusione del ciclo di trattamento. Qualora, dopo il primo tentativo, non si verifichi una gravidanza, verranno valutate le varie fasi della procedura e decise eventuali modificazioni della terapia e/o del tipo di procedura. Per le tecniche di assistenza riproduttiva viene sempre considerato un ciclo di trattamenti e non il singolo tentativo. Questo perché, dopo un mese di rapporti liberi anche una coppia giovane e fertile non ha più del 20% di probabilità di concepire. Mediante le tecniche di assistenza riproduttiva, si supera un ostacolo al concepimento senza poter modificare in modo sostanziale il potenziale di fertilità. Un eventuale insuccesso della metodica, dunque, è valutabile solo dopo almeno 4 tentativi giunti al transfer.
tags: #orologio #per #ovulazione